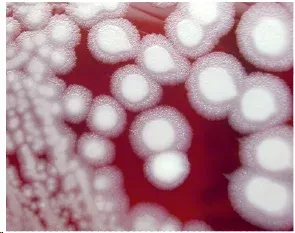
Bacillus anthracis colonies on blood agar

Bacillus & Clostridium - Spore-Forming Rivals
- Gram-positive, endospore-forming rods. Spores are metabolically dormant, highly resistant structures, enabling survival in harsh conditions (e.g., heat, desiccation).
- Primary distinction: Oxygen tolerance.
| Feature | Bacillus | Clostridium |
|---|---|---|
| Oxygen Req. | Aerobic / Facultative Anaerobe | Obligate Anaerobe |
| Catalase | Positive | Negative |
| Spore Position | Central / Paracentral (non-bulging) | Subterminal / Terminal (often bulging) |
| Habitat | Soil, water, air | Soil, GIT of animals/humans |
| Key Pathogens | B. anthracis (anthrax), B. cereus (food poisoning) | C. tetani (tetanus), C. botulinum (botulism), C. perfringens (gas gangrene), C. difficile (pseudomembranous colitis) |
⭐ Many Clostridial diseases are toxin-mediated; these exotoxins are among the most potent poisons known (e.g., botulinum toxin is lethal at nanogram levels).
Bacillus Pathogens - Anthrax & Emetic Ills
- B. anthracis: Gram (+), aerobic, spore-former. Capsule, toxins.
- Virulence: Poly-D-glutamic acid capsule; Anthrax Toxin (PA+EF/LF).
- Edema Toxin (ET): PA+EF → ↑cAMP → Edema.
- Lethal Toxin (LT): PA+LF → MAPKK cleavage → Cell death.
- Clinical Forms:
- Cutaneous: Painless black eschar.

- Inhalational: Hemorrhagic mediastinitis.
⭐ Widened mediastinum (CXR) in inhalational anthrax.
- GI: Rare, severe.
- Cutaneous: Painless black eschar.
- Dx: "Medusa head" colonies. PCR.
- Tx: Ciprofloxacin/Doxycycline.
- Anthrax Pathogenesis:
- Virulence: Poly-D-glutamic acid capsule; Anthrax Toxin (PA+EF/LF).
- B. cereus: Gram (+), spore-former. Food poisoning.
- Emetic form (1-6 hrs): Heat-stable cereulide. Reheated fried rice. Vomiting. 📌 "Rice SICK quick!"
- Diarrheal form (6-15 hrs): Heat-labile toxin. Meats/veg. Diarrhea.
- Other: Ocular infections.
Clostridial Neurotoxins - Tetanic Spasms & Flaccid Paralysis
- Overview: Clostridial Neurotoxins (TeNT & BoNT)
- Potent AB neurotoxins; Zinc-endopeptidases.
- Target: SNARE proteins, disrupting vesicular neurotransmitter release.
- Tetanospasmin (TeNT) - C. tetani
- Pathogenesis: Retrograde axonal transport to CNS (Renshaw cells) → Blocks inhibitory NTs (GABA, glycine) by cleaving Synaptobrevin (VAMP).
- Result: Spastic paralysis.
- Clinical: Trismus (lockjaw), risus sardonicus, opisthotonus. 📌 Tetanus = Tight.

- Botulinum Toxin (BoNT) - C. botulinum
- Pathogenesis: Acts at peripheral NMJ → Blocks Acetylcholine (ACh) release by cleaving SNAP-25, Syntaxin, or Synaptobrevin (serotype-specific).
- Result: Flaccid paralysis.
- Clinical: Descending paralysis (diplopia, dysphagia, dysarthria). Infant botulism (floppy baby).

⭐ Botulinum toxin is the most potent known biological toxin; lethal dose ~1 ng/kg.
Clostridial Tissue/Gut - Gangrene & Gut Wreckers
-
Clostridium perfringens
- Gas Gangrene (Myonecrosis): Rapidly spreading, life-threatening.
- Key toxin: Alpha toxin (Lecithinase, Phospholipase C) → hemolysis, tissue necrosis.
- Symptoms: Crepitus (gas), foul-smelling discharge, severe pain.
- Lab: Nagler's reaction (+), double zone hemolysis on blood agar.
- Food Poisoning: Heat-labile enterotoxin; watery diarrhea.
- Gas Gangrene (Myonecrosis): Rapidly spreading, life-threatening.
-
Clostridium difficile (Clostridioides difficile)
- Antibiotic-Associated Diarrhea (AAD) & Pseudomembranous Colitis (PMC).
- Cause: Gut flora disruption by antibiotics (e.g., clindamycin, cephalosporins).
- Toxins:
- Toxin A (Enterotoxin): Diarrhea, inflammation.
- Toxin B (Cytotoxin): More potent; causes colonic mucosal damage.
- Diagnosis: Stool toxin detection (EIA/PCR for toxins A/B); colonoscopy shows pseudomembranes.
- Treatment: Oral vancomycin, metronidazole, fidaxomicin.
⭐ C. difficile spores are highly resistant, key in hospital infections, causing recurrence.
- Antibiotic-Associated Diarrhea (AAD) & Pseudomembranous Colitis (PMC).
High‑Yield Points - ⚡ Biggest Takeaways
- Bacillus & Clostridium: Gram-positive, spore-forming rods. Bacillus: aerobic; Clostridium: anaerobic.
- B. anthracis: Causes anthrax; key factors: poly-D-glutamate capsule, anthrax toxin.
- B. cereus: Known for food poisoning (emetic/diarrheal).
- C. tetani: Tetanospasmin causes tetanus (spastic paralysis).
- C. botulinum: Botulinum toxin causes botulism (flaccid paralysis); from canned foods, infant honey.
- C. perfringens: Causes gas gangrene, food poisoning; double hemolysis, Nagler reaction.
- C. difficile: Causes pseudomembranous colitis (antibiotic-associated) via Toxins A & B.
Unlock the full lesson and continue reading
Signup to continue reading this lesson and unlimited access questions, flashcards, AI notes, and more